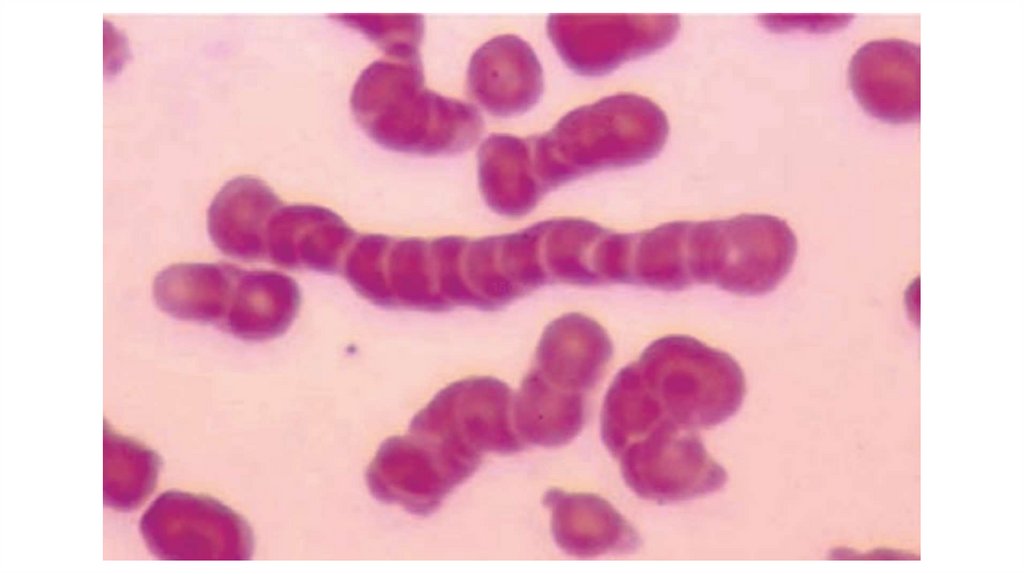

Similar presentations:
Body fluids and blood
1.
Physiologyof body fluids and blood
Jumayev Navruz Shuxratovich
2.
Body Fluids• Body is formed by solids and fluids. Fluid part is more
than two third of the whole body. Water forms most of
the fluid part of the body.
3.
SIGNIFICANCE OF BODY FLUIDSIN HOMEOSTASIS-Body cells survive in the fluid medium called internal
environment. Internal environment contains substances such as
glucose, amino acids, lipids, vitamins, ions, oxygen, etc. which are
essential for growth and functioning of the cell.
IN TRANSPORT MECHANISM-Body water forms the transport medium
by which nutrients and other essential substances enter the cells; and
unwanted substances come out of the cells.
IN METABOLIC REACTIONS-Water inside the cells forms the medium
for various metabolic reactions.
IN TEXTURE OF TISSUES
IN TEMPERATURE REGULATION
4.
COMPARTMENTS OF BODY FLUIDS –DISTRIBUTION OF BODY FLUIDS
1. Intracellular fluid (ICF): Its volume is 22 L and it
forms 55% of the total body water.
2. Extracellular fluid (ECF): Its volume is 18 L and it
forms 45% of the total body water.
5.
COMPOSITION OF BODY FLUIDS• ORGANIC SUBSTANCES
• INORGANIC SUBSTANCES
6.
CONCENTRATION OF BODY FLUIDSConcentration of body fluids is expressed in three
ways:
1. Osmolality - the number of particles (osmoles) per kilogram of
solution (osmoles/kg H2O).
2. Osmolarity - the number of particles (osmoles) per
liter of solution (osmoles/L).
3. Tonicity - Tonicity is the measure of effective osmolality.
7.
In terms of tonicity, the solutions are classifiedinto three categories:
• Hypotonic - Fluid which has less effective osmolality than the body
fluids is called hypotonic fluid
• Isotonic - Fluid which has the same effective osmolality (tonicity) as
body fluids is called isotonic fluid.
• Hypertonic - Fluid which has greater effective osmolality than the
body fluids is called hypertonic fluid
8.
9.
Blood10.
Blood is a connective tissue in fluid form.11.
PROPERTIES OF BLOOD• Color: Blood is red in color. Arterial blood is scarlet red because it
contains more oxygen and venous blood is purple red because of
more carbon dioxide.
• Volume: It is about 8% of the body weight in a normal young healthy
adult, weighing about 70 kg.
• Reaction and pH: Blood is slightly alkaline and its pH in normal
conditions is 7.4.
• Viscosity: Blood is five times more viscous than water. It is mainly due
to red blood cells and plasma proteins.
• Specific gravity: Specific gravity of total blood : 1.052 to 1.061
12.
13.
BLOOD CELLS1. Red blood cells or erythrocytes
2. White blood cells or leukocytes
3. Platelets or thrombocytes.
14.
Hematocrit Value• Volume of red blood cells
expressed in percentage is
called the hematocrit value or
packed cell volume (PCV)
15.
SERUMSerum = Plasma – Fibrinogen
16.
FUNCTIONS OF BLOOD• NUTRITIVE FUNCTION
• RESPIRATORY FUNCTION
• EXCRETORY FUNCTION
• TRANSPORT OF HORMONES AND ENZYMES
• REGULATION OF WATER BALANCE
• REGULATION OF ACID-BASE BALANCE
• REGULATION OF BODY TEMPERATURE
• STORAGE FUNCTION
• DEFENSIVE FUNCTION
17.
Plasma Proteins1. Serum albumin
2. Serum globulin
3. Fibrinogen
Ratio between plasma level of albumin and globulin is
called albumin/globulin (A/G) ratio.
It is an important indicator of some diseases involving
liver or kidney.
Normal A/G ratio is 2 : 1.
18.
PROPERTIES OF PLASMA PROTEINS• MOLECULAR WEIGHT
• ONCOTIC PRESSURE(about 25mmHg)
• SPECIFIC GRAVITY - 1.026
• BUFFER ACTION
19.
FUNCTIONS OF PLASMA PROTEINS• ROLE IN COAGULATION OF BLOOD
• ROLE IN DEFENSE MECHANISM OF BODY
• ROLE IN TRANSPORT MECHANISM
• ROLE IN REGULATION OF ACID-BASE BALANCE
• ROLE IN VISCOSITY OF BLOOD
• ROLE IN ERYTHROCYTE SEDIMENTATION RATE
• ROLE IN SUSPENSION STABILITY OF RED BLOOD CELLS
20.
Red Blood Cells• Red blood cells (RBCs) are the non-nucleated formed elements in the
blood
21.
MORPHOLOGY OF RED BLOOD CELLSThe RBCs are disk shaped and biconcave (dumbbell shaped).
Advantages of Biconcave Shape of RBCs:
- Equal and rapid diffusion of oxygen and other substances
- Large surface area
- Minimal tension is offered on the membrane when the volume of cell
alters.
- RBCs squeeze through the capill_x0002_aries very easily without
getting damaged
22.
23.
RBC has a special type of cytoskeleton, which is made up of actin andspectrin. Both the proteins are anchored to transmembrane proteins
by means of another protein called ankyrin. Absence of spectrin results
in hereditary spherocytosis. In this condition, the cell is deformed,
losses its biconcave shape and becomes globular (spherocytic). The
spherocyte is very fragile and easily ruptured (hemolyzed) in hypotonic
solutions.
24.
25.
VARIATIONS IN NUMBER OF REDBLOOD CELLS
Increase in the RBC count is known as polycythemia.
1. Age
2. High altitude
3. Muscular exercise
4. Emotional conditions
5. Increased environmental temperature
6. After meals
26.
VARIATIONS IN NUMBER OF REDBLOOD CELLS
Decrease in the RBC count:
1. High barometric pressures(the oxygen tension of blood is higher)
2. During sleep
3. Pregnancy(increase in ECF volume)
27.
28.
Erythrocyte sedimentation rate (ESR)• Erythrocyte sedimentation rate (ESR) is the rate at which the
erythrocytes settle down. Normally, the red blood cells (RBCs) remain
suspended uniformly in circulation. This is called suspension stability
of RBCs. If blood is mixed with an anticoagulant and allowed to stand
on a vertical tube, the red cells settle down due to gravity with a
supernatant layer of clear plasma.
29.
Westergren Tube• The tube is 300 mm long and
opened on both ends. It is
marked 0 to 200 mm from above
downwards. Westergren tube is
used only for determining ESR.
30.
Erythropoiesis• Erythropoiesis is the process of the origin, development
and maturation of erythrocytes.
• Development and maturation of erythrocytes require variety of
factors, which are classified into three categories:
- General factors
- Maturation factors
- Factors necessary for hemoglobin formation
31.
GENERAL FACTORS• Erythropoietin
• Thyroxine
• Hemopoietic growth factors(IL-3 secreted by T-cells, IL-6, IL-11)
• Vitamins(B,C,D,E)
32.
MATURATION FACTORS• Vitamin B12 (Cyanocobalamin)
• Intrinsic Factor of Castle (In the stomach)
• Folic Acid
33.
FACTORS NECESSARY FORHEMOGLOBIN FORMATION
• First class proteins and amino acids: Proteins of high biological value are
essential for the formation of hemoglobin. Amino acids derived from these
proteins are required for the synthesis of protein part of hemoglobin, i.e. the
globin.
• Iron: Necessary for the formation of heme part of the hemoglobin.
• Copper: Necessary for the absorption of iron from the gastrointestinal tract.
• Cobalt and nickel: These metals are essential for the utilization of iron during
hemoglobin formation.
• Vitamins: Vitamin C, riboflavin, nicotinic acid and pyridoxine are also essential
for the formation of hemoglobin.
34.
White Blood Cells• White blood cells (WBCs) or leukocytes are the colorless
and nucleated formed elements of blood (leuko is derived
from Greek word leukos = white).
35.
CLASSIFICATIONSome of the WBCs have granules in the cytoplasm. Based on the presence or
absence of granules in the cytoplasm, the leukocytes are classified into two
groups:
1. Granulocytes which have granules.
- Neutrophils with granules taking both acidic and basic stains.
- Eosinophils with granules taking acidic stain.
- Basophils with granules taking basic stain.
2. Agranulocytes which do not have granules.
- Monocytes.
- Lymphocytes.
36.
37.
38.
39.
40.
41.
42.
Hemostasis• Hemostasis is defined as arrest or stoppage of bleeding
stoppage
Hemo stasis
blood
43.
STAGES OF HEMOSTASIS1. Vasoconstriction
2. Platelet plug formation
3. Coagulation of blood.
44.
VASOCONSTRICTIONImmediately after injury, the blood vessel constricts and decreases the
loss of blood from damaged portion. Usually, arterioles and small
arteries constrict. Vasoconstriction is purely a local phenomenon.
When the blood vessels are cut, the endothelium is damaged and the
collagen is exposed. Platelets adhere to this colla_x0002_gen and get
activated. The activated platelets secrete serotonin and other
vasoconstrictor substances which cause constriction of the blood
vessels. Adherence of platelets to the collagen is accelerated by von
Willebrand factor. This factor acts as a bridge between a specific
glycoprotein present on the surface of platelet and collagen fibrils.
45.
PLATELET PLUG FORMATIONPlatelets get adhered to the collagen of ruptured blood vessel and
secrete adenosine diphosphate (ADP) and thromboxane A2. These two
substances attract more and more platelets and activate them. All
these platelets aggre_x0002_gate together and form a loose temporary
platelet plug or temporary hemostatic plug, which closes the ruptured
vessel and prevents further blood loss. Platelet aggrega_x0002_tion is
accelerated by plateletactivating factor (PAF).
46.
COAGULATION OF BLOOD• During this process, the fibrinogen is converted into fibrin. Fibrin
threads get attached to the loose platelet plug, which blocks the
ruptured part of blood vessels and prevents further blood loss
completely. Mechanism of blood coagulation is explained in the next
chapter.
47.
48.
Coagulation of Blood• STAGE 1: FORMATION OF PROTHROMBIN ACTIVATOR
• STAGE 2: CONVERSION OF PROTHROMBIN INTO THROMBIN
• STAGE 3: CONVERSION OF FIBRINOGEN INTO FIBRIN

biology
biology








